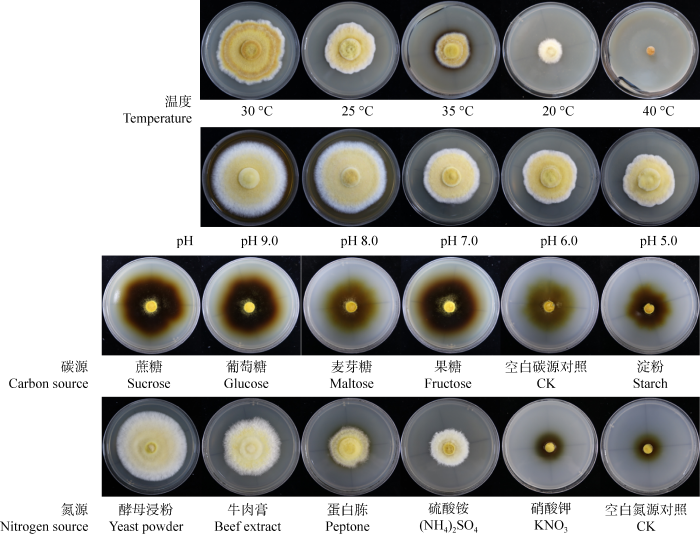
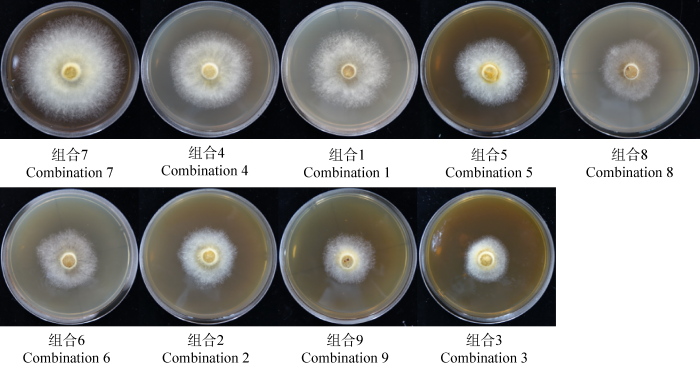

粗毛纤孔菌Inonotus hispidus (Bull.) P. Karst.俗称粗毛黄褐孔菌或粗毛黄孔菌,新疆南部又称“桑黄”,是隶属于真菌界Fungi、担子菌门Basidiomycota、蘑菇纲Agaricomycetes、锈革孔菌目Hymenochaetales、锈革孔菌科Hymenochaetaceae的一种木腐菌(戴玉成2005;Wu et al. 2022),寄主主要有水曲柳Fraxinus mandshurica、桑树Morus alba、杨树Populus和榆树Ulmus pumila 等,西北地区常见于桑树,东北则常见于水曲柳(戴玉成等2000),我国主要分布在北温带地区(昝立峰和包海鹰2011;戴玉成2012)。根据有关学者对粗毛纤孔菌形态特征、生境及药用功效的研究,认为该菌是传统中药“桑黄”的正源(包海鹰等2017)。
粗毛纤孔菌作为药用真菌已在中国民间广泛用于治疗癌症、肝病、糖尿病、胃病和痛风等(戴玉成和图力古尔2007)。国内外大量研究表明粗毛纤孔菌集抗病毒、降血糖、抗肿瘤、降血脂以及抗炎抑菌等多种功能于一身(Ali et al. 1996, 2003;昝立峰等2012;Gründemann et al. 2017;李德海等2018;杨树东等2019;Wu et al. 2019),抗氧化能力被视为这些作用的基础,人类许多疾病和衰老都与体内自由基代谢、氧化应激和抗氧化状态密切相关,如何增强机体对这些有害因素的抵抗力成为目前人们关注的热点之一。恰当地摄入抗氧化剂能保护人体不受氧化损伤,天然抗氧化剂无毒副作用,其可作为食品添加剂、药品、保健品及化妆品添加剂使用。
粗毛纤孔菌是一种优良的生物抗氧化制剂,在医药、化工及食品工业中都有广泛应用前景。由于其具有良好的应用价值和经济价值,国内外已逐渐开始重视并进行了一些试验研究工作。因此,开展粗毛纤孔菌生物学特性和抗氧化活性的深入系统研究,揭示粗毛纤孔菌的药理作用具有重要意义。本研究拟通过固体平板培养法,对实验室前期收集并保存的野生粗毛纤孔菌菌株进行固体培养最适培养温度、初始pH、碳源和氮源的研究,并通过液体发酵培养法测定其培养液中多酚、黄酮、抑制羟自由基、DPPH自由基清除率、ABTS自由基清除率及铁离子还原作用来评价粗毛纤孔菌抗氧化活性,为该药用真菌功能产品开发及应用提供理论依据。
1 材料与方法
1.1 实验菌株
粗毛纤孔菌菌株(Dai 8299),现保藏于北京林业大学微生物研究所。
1.2 培养基
加富PDA培养基配方(g/L):去皮土豆200.0,葡萄糖20.0,蛋白胨5.0,KH2PO4 1.0,琼脂20.0,VB1 0.01,pH自然。无碳源培养基配方(g/L):KNO3 5.0,KH2PO4 1.0,琼脂20.0,VB1 0.01,pH自然。无氮源培养基配方(g/L):葡萄糖20.0,KH2PO4 1.0,琼脂20.0,VB1 0.01,pH自然。液体培养基配方(g/L):葡萄糖20.0,酵母浸粉5.0,KH2PO4 1.0,MgSO4∙7H2O 0.5,VB1 0.01,pH自然。
1.3 固体活化培养
将按配方制备的培养基于灭菌锅121 ℃、1×105 Pa灭菌30min备用。将4 ℃保存在固体试管斜面培养基中的粗毛纤孔菌转接到固体加富PDA平板培养基上活化,在28 ℃恒温培养箱中培养后备用。
1.4 生物学特性研究
待活化的菌丝长满平板后,在超净工作台下将直径1 cm、菌丝长势基本一致的菌饼接种到供试培养基上,每个处理5次重复。自菌丝体接种后第2日起,每日固定时间用十字交叉法测定菌落直径,并记录菌丝体长势及菌落状况至生长最迅速的菌丝体即将覆盖平板为止。
1.4.1 最适温度
接种于加富PDA培养基后,在20、25、30、35和40 ℃的恒温培养箱中黑暗培养。
1.4.2 最适初始pH
以加富PDA培养基为基础,灭菌前利用提前配制好的1 mol/L HCl和1 mol/L NaOH调节培养基的pH至5.0、6.0、7.0、8.0和9.0,接种后在恒温培养箱中28 ℃黑暗培养。
1.4.3 最适碳源
按照无碳源培养基的配方,添加20.0 g/L葡萄糖、果糖、蔗糖、麦芽糖、淀粉及空白碳源对照控制不同碳源来制备培养基,接种后在恒温培养箱中28 ℃黑暗培养。
1.4.4 最适氮源
按无氮源培养基的配方,添加5.0 g/L KNO3、(NH4)2SO4、酵母浸粉、蛋白胨、牛肉膏及空白氮源对照控制不同氮源来制备培养基,接种后在恒温培养箱中28 ℃黑暗培养。
1.4.5 正交试验
选取单因素试验得出的培养基最适碳源(A1、A2、A3)、氮源(B1、B2、B3)和初始pH (C1、C2、C3)进行L9 (33)三因素三水平正交试验,确定最优组合(表1)。
表1 正交实验因素水平表
Table 1
| 水平 Levels | 因素 Factors | ||
|---|---|---|---|
| A (碳源) Carbonic source (g/L) | B (氮源) Nitrogen source (g/L) | C (初始pH) Initial pH value | |
| 1 | 10.0 | 1.0 | 8.0 |
| 2 | 20.0 | 5.0 | 9.0 |
| 3 | 30.0 | 9.0 | 10 |
1.5 种子发酵及液体培养
待活化的菌丝长满平板后,用打孔器从边缘取出5块直径10 mm的菌块,接种于装有100 mL液体培养基的250 mL锥形瓶内,摇床28 ℃、150 r/min振荡培养,直至菌丝球良好发酵。在超净工作台上用内切式匀浆机把培养的种子液彻底粉碎成均匀菌悬液后进行发酵,用移液枪吸取10 mL的种子液,接种到盛有100 mL液体培养基的250 mL锥形瓶内,摇床28 ℃、150 r/min振荡培养14 d,设置3个重复。
在14 d的液体发酵过程中,每隔2 d取1瓶样品,抽滤整瓶培养物,所得菌丝体在无菌水中淋洗,然后在烘箱中65 ℃干燥至恒重,称重并计算菌丝体生物量;培养液经4 ℃、12 000 r/min离心20 min,吸取上清液测定其抗氧化活性。
1.6 抗氧化活性研究
1.6.1 多酚含量
采用Folin-Ciocalteu试剂法,以邻苯三酚为标准物质,标准曲线法(张梅梅等2011)定量测定。所得标准曲线为y=2.762 2x+0.012 3,相关系数R2=0.997 1。
吸取1.0 mL培养液,加等量的乙酸乙酯反复提取3次,合并浓缩定容至5.0 mL (Zheng et al. 2009),吸取0.7 mL浓缩定容液与0.3 mL 1.0 mol/L福林酚试剂混合,黑暗条件下反应8 min,然后加入0.6 mL 10% (质量体积分数) Na2CO3溶液,在25 ℃黑暗条件下反应30 min。最后用去离子水定容到5.0 mL,在750 nm处测定吸光值。用去离子水代替反应体系中的培养液,将福林酚试剂分别作为空白和对照,最后带入标准曲线中以邻苯三酚为当量计算培养液中多酚含量。
1.6.2 黄酮含量
采用亚硝酸钠-硝酸铝法,芦丁作标准物质,标准曲线法(Zhu et al. 2011)定量测定。所得标准曲线为y=0.016 6x-0.036,相关系数为R²=0.991。
吸取1.0 mL培养液,加6.0 mL 70% (体积分数)乙醇和1.0 mL 5% (质量体积分数) NaNO2溶液,充分搅拌均匀后静置6 min,加1.0 mL 10% (质量体积分数) Al(NO3)3溶液搅拌均匀后继续静置6 min,再加10.0 mL 4% (质量体积分数) NaOH溶液,用70% (体积分数)乙醇定容至25.0 mL,搅拌均匀后静置15 min,在510 nm处测吸光值。用70% (体积分数)乙醇替代反应体系中的培养液,将芦丁标准液分别作为空白和对照,带入标准曲线中以芦丁为当量计算上清液中黄酮类化合物含量。
1.6.3 羟自由基清除能力
采用南京建成生物工程研究所的测定试剂盒。抑制羟自由基能力是指每毫升发酵液在37 ℃条件下经1 min反应,将下降1 mmol/L反应体系内的H2O2浓度作为1个抑制羟自由基能力单位。
1.6.4 DPPH自由基清除能力
参考Brand-Williams et al.(1995)的方法,略作修改。0.2 mmol/L的DPPH溶液由精确称取的0.02 g DPPH溶于无水乙醇中后定容至250.0 mL来制备。设置空白组A0 (2.0 mL无水乙醇+ 2.0 mL 0.2 mmol/L DPPH溶液)、样品组A1 (2.0 mL上清液+2.0 mL 0.2 mmol/L DPPH溶液)、对照组A2 (2.0 mL上清液+2.0 mL无水乙醇),充分混合后于黑暗条件25 ℃反应30 min,测定517 nm处的吸光度。设置3个平行,取平均值。计算公式:DPPH自由基清除率(%)=[1- (A1-A2)/A0]×100,其中:A0为以无水乙醇替代样品的反应体系的吸光度,A1为添加样品的反应体系的吸光度,A2为以无水乙醇替代DPPH的反应体系的吸光度。
1.6.5 ABTS自由基清除能力
参考Miller et al. (1993)的方法,略作修改。ABTS+母液由制备的2.45 mmol/L过硫酸钾水溶液和7.0 mmol/L ABTS溶液搅拌混合后,在黑暗条件25 °C放置10-16 h得到。ABTS+工作液由ABTS+母液经去离子水稀释直至其在734 nm处的吸光值为0.700±0.023后,在30 ℃下静置30 min得到。设置空白组B0 (2.0 mL去离子水+ 2.0 mL ABTS+工作液)、样品组B1 (2.0 mL上清液+2.0 mL ABTS+工作液)、对照组B2 (2.0 mL上清液+2.0 mL去离子水),充分混合于25 ℃黑暗中反应20 min后测定734 nm处的吸光度。设置3个平行,取其平均值。计算公式:ABTS自由基清除率(%)=[1-(B1-B2)/B0]×100,式中:B0为以去离子水替代样品的反应体系的吸光度,B1为添加样品的反应体系的吸光度,B2为以去离子水替代ABTS的反应体系的吸光度。
1.6.6 铁离子还原能力
参考Benzie & Strain (1996)的方法,略作修改。以FeSO4为标准液,标准曲线法定量测定。所得标准曲线为y=0.004 7x+0.163,相关系数为R²=0.997 8。
FRAP工作液由0.3 mol/L乙酸-醋酸钠缓冲液(pH 3.6)、0.01 mol/L TPTZ (溶于0.04 mol/L盐酸)和0.02 mol/L FeCl3以10:1:1混合而成。设置空白组C0 (0.5 mL蒸馏水+3.0 mL FRAP工作液)、样品组C1 (0.5 mL上清液+3.0 mL FRAP工作液)、对照组C2 (0.5 mL上清液+3.0 mL蒸馏水),充分混合后于37 ℃黑暗中反应15 min,测定593 nm处的吸光度。C1-C0-C2之差在标准曲线中所得对应FeSO4当量浓度即得FRAP值。
1.7 统计分析
采用多次平行实验的平均值±标准差来表示生物学特性实验和抗氧化活性实验所获得的数据结果。采用SPSS 26.0软件对数据进行单因素方差分析(ANOVA)等,P<0.05为差异显著。
2 结果与分析
2.1 生物学特性研究
2.1.1 不同温度对粗毛纤孔菌菌丝生长的 影响
图1
图1
不同温度下培养粗毛纤孔菌的菌落直径变化
Fig. 1
Colony diameter of Inonotus hispidus under different culture temperatures in different incubation period.
表2 不同单因子条件对粗毛纤孔菌菌丝生长的影响
Table 2
| 培养条件 Condition | 因子 Factor | 菌落直径 Colony diameter (mm) | 显著性 Significance | 菌丝长势 Mycelial growth vigor | |
|---|---|---|---|---|---|
| 0.05 | 0.01 | ||||
| 温度 Temperature (°C) | 30 | 62.89±8.46 | a | A | ++++ |
| 25 | 48.61±6.02 | b | B | +++ | |
| 35 | 34.57±3.42 | c | C | ++ | |
| 20 | 26.97±0.78 | d | C | ++ | |
| 40 | 10.00±0.00 | e | D | − | |
| pH | 9.0 | 71.80±2.22 | a | A | ++++ |
| 8.0 | 68.14±1.08 | a | A | ++++ | |
| 7.0 | 55.39±2.54 | b | B | +++ | |
| 6.0 | 49.97±6.02 | c | B | +++ | |
| 5.0 | 49.59±1.76 | c | B | +++ | |
| 碳源 Carbon source | 蔗糖Sucrose | 62.53±3.90 | a | A | ++ |
| 葡萄糖Glucose | 61.52±4.83 | ab | A | ++ | |
| 麦芽糖Maltose | 60.03±1.69 | ab | A | + | |
| 果糖Fructose | 59.25±2.87 | ab | A | ++ | |
| 空白碳源对照CK | 57.67±2.61 | b | A | + | |
| 淀粉Starch | 52.21±1.46 | c | B | + | |
| 氮源 Nitrogen source | 酵母浸粉Yeast powder | 73.45±4.07 | a | A | ++++ |
| 牛肉膏Beef extract | 56.55±2.69 | b | B | +++ | |
| 蛋白胨Peptone | 42.91±2.44 | c | C | ++ | |
| 硫酸铵(NH4)2SO4 | 37.58±1.77 | d | D | ++ | |
| 硝酸钾KNO3 | 34.90±1.25 | d | D | + | |
| 空白氮源对照CK | 34.37±1.23 | d | D | + | |
++++表示菌丝体极密;+++表示菌丝体密;++表示菌丝体稀;+表示菌丝体极稀;−表示菌丝不生长. 同列内不同小写字母和大写字母分别代表差异显著(P<0.05)和差异极显著(P<0.01)
++++ Represents quite vigorous growth; +++ Represents vigorous growth; ++ Rrepresents weak growth; + Represents very weak growth; − Represents no growth. Different lowercase and uppercase letters in the same column represent significant differences (P<0.05) and extremely significant differences (P<0.01), respectively.
2.1.2 不同初始pH对粗毛纤孔菌菌丝生长的影响
粗毛纤孔菌菌丝于不同的初始pH条件下均可生长,且呈现出不同的生长速度,由大到小依次为pH 9.0>pH 8.0>pH 7.0> pH 6.0>pH 5.0 (图2,图5)。培养至第8天时,pH 9.0组的菌落直径最大,平均直径为(71.80±2.22) mm。培养的粗毛纤孔菌于不同初始pH下的第8天菌落直径的方差分析见表2,结果表明,粗毛纤孔菌菌丝生长速度因初始pH不同存在显著差异。多重比较发现,对菌落直径的影响因素中pH 9.0组与pH 8.0组之间无显著差异,但二者与其他初始pH处理之间又差异极其显著。因此,该菌菌丝适合于碱性的培养基生长,合适生长的初始pH在8.0-9.0。综合考虑,初始pH 9.0更适合粗毛纤孔菌的菌丝生长。
图2
图2
粗毛纤孔菌菌落直径在不同初始pH下的生长变化
Fig. 2
Colony diameter of Inonotus hispidus under different initial pH value in different incubation period.
2.1.3 不同碳源对粗毛纤孔菌菌丝生长的影响
图3
图3
粗毛纤孔菌菌落直径在不同碳源下的生长变化
Fig. 3
Colony diameter of Inonotus hispidus under different carbon sources in different incubation period.
2.1.4 不同氮源对粗毛纤孔菌菌丝生长的影响
图4
图4
粗毛纤孔菌菌落直径在不同氮源下的生长变化
Fig. 4
Colony diameter of Inonotus hispidus under different nitrogen sources in different incubation period.
图5
图5
不同单因子条件对粗毛纤孔菌菌丝生长的影响
Fig. 5
The effects of various single factors on the mycelial growth of Inonotus hispidus.
2.1.5 最佳因子组合
用单因素试验得出的最适碳源(蔗糖)、氮源(酵母浸粉)和初始pH作三因素三水平正交试验(表3)。通过直观分析发现,粗毛纤孔菌的菌丝生长速度及菌丝长势因正交组合的不同而存在差异(图6),其中第7个组合(A3B1C3)菌丝长速最高,为(6.662 2±0.42) mm/d。碳源含量、氮源含量及初始pH三者之间的极差R分别为0.578 4、1.745 7及0.347 7,因此,粗毛纤孔菌菌丝长速影响因素依次为:氮源含量>碳源含量>初始pH;同时还对三因素之间的均值进行排序,碳源含量为X3>X2>X1,氮源含量为X1>X2>X3,初始pH为X3>X1>X2,综合以上可以得出最佳组合为A3B1C3,即蔗糖30 g/L、酵母浸粉1 g/L、初始pH 10.0。
表3 正交试验结果
Table 3
| 编号 Serial number | 因素 Factors | ||||
|---|---|---|---|---|---|
| A (碳源) Carbon source (g/L) | B (氮源) Nitrogen source (g/L) | C (初始pH) Initial pH value | 菌丝长速 Mycelium growth rate (mm/d) | 菌丝长势 Mycelium growth vigor | |
| 1 | 10.0 | 1.0 | 8.0 | 5.440 2±0.36 | ++ |
| 2 | 10.0 | 5.0 | 9.0 | 4.517 4±0.18 | ++ |
| 3 | 10.0 | 9.0 | 10.0 | 3.765 8±0.36 | ++ |
| 4 | 20.0 | 1.0 | 9.0 | 5.589 6±0.26 | +++ |
| 5 | 20.0 | 5.0 | 10.0 | 4.795 4±0.31 | +++ |
| 6 | 20.0 | 9.0 | 8.0 | 4.615 8±0.73 | + |
| 7 | 30.0 | 1.0 | 10.0 | 6.662 2±0.42 | ++++ |
| 8 | 30.0 | 5.0 | 8.0 | 4.723 0±0.20 | + |
| 9 | 30.0 | 9.0 | 9.0 | 4.073 4±0.43 | ++ |
| K1 | 13.723 4 | 17.692 0 | 14.779 0 | ||
| K2 | 15.000 8 | 14.035 8 | 14.180 4 | ||
| K3 | 15.458 6 | 12.455 0 | 15.223 4 | ||
| X1 | 4.574 5 | 5.897 3 | 4.926 3 | ||
| X2 | 5.000 3 | 4.678 6 | 4.726 8 | ||
| X3 | 5.152 9 | 4.151 7 | 5.074 5 | ||
| R | 0.578 4 | 1.745 7 | 0.347 7 | ||
++++表示菌丝体极密;+++表示菌丝体密;++表示菌丝体稀;+表示菌丝体极稀
++++ Represents quite vigorous growth; +++ Represents vigorous growth; ++ Represents weak growth; + Represents very weak growth.
图6
图6
正交试验下第10天培养的粗毛纤孔菌生长状态
Fig. 6
Inonotus hispidus growth state under orthogonal test on the 10 th day.
对正交试验结果进行三因素方差分析(表4),不同水平的碳源含量(F=0.931, P=0.518> 0.05)、氮源含量(F=8.309, P=0.107>0.05)和初始pH (F=0.315, P=0.760>0.05)对粗毛纤孔菌菌丝长速影响均不显著,但从F值的大小可以得出与极差分析一致的结果:氮源含量>碳源含量>初始pH。
表4 正交试验方差分析表
Table 4
| 变差来源 Source | 平方和 Sum of squares | 自由度 df | 均方 Mean square | F | 显著性 Significance |
|---|---|---|---|---|---|
| 修正模型Model | 5.532a | 6 | 0.922 | 3.185 | 0.258 |
| 截距Intercept | 216.902 | 1 | 216.902 | 749.281 | 0.001 |
| 碳源Carbon source | 0.539 | 2 | 0.270 | 0.931 | 0.518 |
| 氮源Nitrogen source | 4.810 | 2 | 2.405 | 8.309 | 0.107 |
| 初始pH Initial pH value | 0.183 | 2 | 0.091 | 0.315 | 0.760 |
| 误差Error | 0.579 | 2 | 0.289 | ||
| 总计Total | 223.013 | 9 | |||
| 修正后总计Corrected total | 6.111 | 8 |
模型判定系数R2=0.905,校正后判定系数R2=0.621
The coefficient of determination R2 is 0.905, and the adjusted coefficient of determination R2 is 0.621.
2.2 抗氧化活性研究
2.2.1 粗毛纤孔菌液体培养过程中多酚含量的变化
多酚类化合物常见于植物与高等真菌的次生代谢物中,被鉴定为具有一个或多个“酸”性酚羟基的芳香族天然化合物,对于规避对环境胁迫所造成的一些不利影响有重要意义,且具有良好的抗氧化活性。粗毛纤孔菌在液体培养过程中的多酚含量在前2-4 d呈递增趋势,至第4天达高峰,为(5.73±0.16) μg/mL,随后又有所减少,第14天为(3.31±0.01) μg/mL,仍维持较高水平(图7),其原因可能是菌株暂时无需依赖酚代谢抵抗环境氧化胁迫而使多酚含量减少。
图7
图7
粗毛纤孔菌液体培养过程中多酚含量的变化
Fig. 7
Variation of polyphenol content during liquid cultivation of Inonotus hispidus.
2.2.2 粗毛纤孔菌液体培养过程中黄酮含量的变化
黄酮类化合物是一类母核为黄酮(2-苯基色原酮类化合物)的黄色色素,因其具备维生素C样的活性而曾被认为维生素P,有着明显的抗氧化活性。粗毛纤孔菌在液体培养过程中的黄酮含量没有发生有规律的变化,且前后差异不是很大,始终保持稳定和较高的水平(图8)。同样是次级代谢物,粗毛纤孔菌的黄酮分泌量相比多酚分泌量更多,可能因为该菌株更倾向于分泌黄酮来抵抗环境胁迫。
图8
图8
粗毛纤孔菌液体培养过程中黄酮含量的变化
Fig. 8
Variation of flavonoid content during liquid cultivation of Inonotus hispidus.
2.2.3 粗毛纤孔菌液体培养过程中抑制羟自由基能力的变化
羟自由基(·OH)是一种能够刺激油脂发生过氧化反应且广泛存在于机体内的强氧化剂,会破坏生物膜的结构和功能,是目前已知对生物体危害最大的自由基。粗毛纤孔菌在初始2-6 d内抑制羟自由基能力变化不大,保持在55 U/mL以上,但是自第8天起开始迅速升高进而趋于平稳状态(图9),并在第12天达到最大值(80.68±3.01) U/mL,说明该菌株在一定条件下可以达到很强的抗氧化能力。
图9
图9
粗毛纤孔菌液体培养过程中抑制羟自由基能力的变化
Fig. 9
Variation of inhibitory ability of hydroxyl radical during liquid cultivation of Inonotus hispidus.
2.2.4 粗毛纤孔菌液体培养过程中DPPH自由基清除率的变化
DPPH自由基(二苯代苦味酰基自由基)在有机溶剂中能够一直处于稳定状态,因此DPPH法以其简单、快速和灵敏等优点被广泛应用于抗氧化活性的评价。粗毛纤孔菌在初始2-8 d内可能处于适应环境状态,随着菌株的生长代谢,DPPH自由基清除率先下降然后又缓慢上升,在第8天达到与初始第2天相近的值,第10天则快速升高,达到第一个峰值72.32%±4.53%,而在第12天又迅速下降至34.09%±1.86%,随后在第14天达到最大值75.99%±2.00% (图10),可能是因为该菌株生长到晚期开始降解并影响其相关抗氧化能力的缘故,但是环境压力使得菌株为了保护机体不受损害而重新激活了相关抗氧化机制,从而表现出较高的DPPH清除率。
图10
图10
粗毛纤孔菌液体培养过程中DPPH自由基清除率的变化
Fig. 10
Variation of DPPH radical scavenging efficiency during liquid cultivation of Inonotus hispidus.
2.2.5 粗毛纤孔菌液体培养过程中ABTS自由基清除率的变化
单阳离子ABTS+·自由基由ABTS通过氧化作用而形成,其在734 nm处的最大吸收峰处形成一个蓝/绿发色团。抗氧化物质能将ABTS+·还原为ABTS,并降低其吸光值。本方法简便快捷,适合大量样品的检测。然而ABTS+·在与氢原子供体的反应中选择性较低,它可以与任何羟基化的芳香族化合物发生反应,因此ABTS清除率也包括了对抗氧化不起作用的羟基,但ABTS作为一类重要的外源性自由基,测定其清除能力仍具有一定参考意义。本试验虽然在ABTS自由基清除率方面的结果存在较大误差,但是能明显看出ABTS自由基的清除率十分高,其最低值也有71.12%±16.76%,最高可达96.53%±0.00% (图11),这进一步说明本研究中的粗毛纤孔菌具有较高的抗氧化活性。
图11
图11
粗毛纤孔菌液体培养过程中ABTS自由基清除率的变化
Fig. 11
Variation of ABTS radical scavenging efficiency during liquid cultivation of Inonotus hispidus.
2.2.6 粗毛纤孔菌液体培养过程中铁离子还原能力的变化
铁离子还原能力(ferric reducing antioxidant power, FRAP)以氧化还原反应比色法为基础,在酸性条件下能抑制某些内源性干扰因素,具有简单快速、重复性好等特点。粗毛纤孔菌在液体培养过程中FRAP值整体上在前12 d呈上升趋势,在第12天达到最大值(261.35±26.92) μmol/L,到第14天又下降(图12),这可能是由于菌株培养后期开始退化,生长代谢变慢导致抗氧化能力也相应降低。
图12
图12
粗毛纤孔菌液体培养过程中铁离子还原能力的变化
Fig. 12
Variation of ferric reducing antioxidant power during liquid cultivation of Inonotus hispidus.
2.2.7 活性物质与抗氧化能力相关性分析
图13
图13
粗毛纤孔菌多酚含量和抗氧化能力相关性分析
Fig. 13
Correlation analysis between polyphenol content and antioxidant activities of Inonotus hispidus.
图14
图14
粗毛纤孔菌黄酮含量和抗氧化能力相关性分析
Fig. 14
Correlation analysis between flavonoid content and antioxidant activities of Inonotus hispidus.
许多研究认为粗毛纤孔菌体内的主要抗氧化物质为多酚和黄酮。本研究结果却显示多酚和黄酮分别与抑制羟自由基、DPPH自由基、ABTS自由基清除能力以及铁离子还原能力之间的相关性较差,黄酮含量与铁离子还原能力之间虽有一定相关性但线性拟合程度较差。粗毛纤孔菌表现出较强的抗氧化活性,而本研究的结果却表明多酚和黄酮与其抗氧化能力无明显关系,这可能是由于生物体内与生物体外抗氧化活性成分存在差异所致,抗氧化活性成分的高低除与其本身的结构性质有关外,还依赖于抗氧化活性成分对底物的作用、溶解分散能力、温度、协同效应和增效效应。所以可以认为,单一成分对于抗氧化活性并不能起到决定性的影响,但是通过多种化合物组合后才会表现出明显的效果。因此,对粗毛纤孔菌抗氧化活性的影响可能不仅在于这2个成分单独的作用,更在于其多成分之间的复合作用。
3 讨论
现代药理学研究表明粗毛纤孔菌的子实体、菌丝体和发酵液中均含有多糖类、黄酮类、多酚类和三萜类化合物,具有抗氧化、清除自由基、抗肿瘤、降血糖、降血脂和抗炎抑菌等显著作用,引起国内外学者的重视,并开展了大量生物活性和活性物质的研究,抗肿瘤活性最被重视,其次是抗氧化作用。目前,粗毛纤孔菌的研究多集中在子实体及其提取物,粗毛纤孔菌野生子实体资源缺乏,人工栽培困难,获取效率较低,制约了该菌的进一步开发和利用。如何高效地利用这
些资源以提高粗毛纤孔菌群的产量成为亟待解决的问题之一,因此本研究采用固体培养方式,以菌丝生长速度为指标,考察不同培养基配方对菌体生物量的影响,筛选出最佳培养基组成。液体发酵是现代发酵工程发展的一个重要方向,其优点是生产周期短、操作简便、无季节气候限制、能进行大规模工业化生产及易于获取大量所需产物等(郑飞等2017),成为积累粗毛纤孔菌生产活性物质的重要途径之一。因此,本研究也评价了粗毛纤孔菌液体培养抗氧化活性,希望能为药用真菌功能性成分的提取及产品开发应用提供理论依据。
通过培养温度、初始pH、碳源及氮源4个单因素试验,发现粗毛纤孔菌固体培养时的最适培养温度为30 ℃、初始pH为9.0、碳源为蔗糖、氮源为酵母浸粉。菌丝培养方法主要分为液体培养和固体培养2种,不同方法的培养条件对菌丝体的生长以及产物含量等都有很大的影响。在粗毛纤孔菌的液体培养方面,陈向东和兰进(2010)从胞外多糖产量和菌丝体生物量两方面来评价,研究表明,葡萄糖、酵母膏、初始pH值于6.5-7.5时生长状况最好,而pH<4.5或>9.0时菌丝几乎没有生长。在固体培养方面,谢凤颖等(2012)研究发现粗毛纤孔菌菌丝在碳源为蔗糖、氮源为谷氨酸、温度为20-25 ℃、初始pH为8-8.5和避光时生长最好,同时对几种常见培养基进行研究,发现在PDA培养基上生长最好;王婷等(2016)研究发现寄生蒙古黄榆的粗毛纤孔菌最适宜的生长温度是30 ℃、初始pH是6.5、碳源是木糖、氮源是酵母浸粉;刘鑫等(2018)研究发现寄生宁夏枣树的粗毛纤孔菌最适宜生长温度是25 ℃、初始pH是6.0、碳源是葡萄糖、氮源是酵母浸粉。可以看到,粗毛纤孔菌相关菌丝培养研究结果各异,总体来说更适合在简单碳源、有机氮源上生长,而最适pH、最适温度的不同可能与实验菌种采集地、寄生树种的不同相关。
一般来说,植物与高等真菌的抗氧化作用与多酚含量和黄酮含量关系密切,表现为清除羟自由基(·OH)、DPPH自由基和ABTS自由基能力及铁离子还原能力(FRAP) (李雨沁2010)。多酚类物质是粗毛纤孔菌子实体的主要色素类成分,主要为hispidin、hispolon、bis-noryangonin、hypholomine B和3,14-bihispidinyl,都具有良好的抗氧化活性(Fiasson 1982;Gill 2003;昝立峰2012;Hou et al. 2019;李志军和包海鹰2020)。昝立峰等(2015)对粗毛纤孔菌子实体甲醇提取物进行了15种单体化合物的分离,其中有hispolon、hispidin、inonotusin A、inonotusin B、4-(3,4-二羟苯基)-3-丁烯-2-酮、inoscavin C、inoscavin D、原儿茶醛和原儿茶酸9个多酚类物质,并发现该菌70%乙醇提取物和hispidin、inonotusin A和inonotusin B对DPPH和·OH自由基有较强清除作用。黄酮也是粗毛纤孔菌抗氧化活性中的重要活性成分,陈志娜等(2018)研究发现,粗毛纤孔菌子实体在乙酸乙酯、70%乙醇、甲醇、氯仿这些不同溶剂的提取物中的黄酮含量、多酚含量和抗氧化活性方面具有显著差异,甲醇提取物中多酚和黄酮的含量最多,抗氧化活性最强。本研究发现粗毛纤孔菌在液体培养的14 d内,多酚和黄酮含量一直处于较高水平,且对羟自由基、DPPH自由基、ABTS自由基清除能力以及铁离子还原能力也较强,说明粗毛纤孔菌具有良好的抗氧化活性,可以作为一类天然抗氧化剂开发使用。将粗毛纤孔菌液体培养液中的活性物质与抗氧化能力通过一元线性回归模型分析,结果显示其培养液中的多酚含量和黄酮含量与抗氧化能力相关性较差,说明最终影响粗毛纤孔菌的抗氧化活性可能不只是这2种成分单独的作用,而是多个成分之间的复合作用。
综上所述,通过对野外分离的一种药用真菌粗毛纤孔菌Inonotus hispidus进行的生物学特性与抗氧化活性研究,根据单因子、正交试验结果得到,适合该菌株菌丝生长的最适碳源为蔗糖30 g/L、氮源为酵母浸粉1 g/L、初始pH 10.0。同时测定了粗毛纤孔菌液体培养时的多酚、黄酮含量以及对羟自由基、DPPH自由基、ABTS自由基的清除能力和铁离子还原能力,结果发现粗毛纤孔菌表现出较好的抗氧化活性。本研究为药用真菌粗毛纤孔菌的开发利用提供了一定的依据。
参考文献
Inhibition of chemiluminescence response of human mononuclear cells and suppression of mitogen-induced proliferation of spleen lymphocytes of mice by hispolon and hispidin
Antiviral activity of Inonotus hispidus
DOI:10.1016/S0367-326X(03)00119-9 URL [本文引用: 1]
Supplementary textual research on sanghuang
The ferric reducing ability of plasma (FRAP) as a measure of “antioxidant power”: the FRAP assay
DOI:10.1006/abio.1996.0292
PMID:8660627
[本文引用: 1]

A simple, automated test measuring the ferric reducing ability of plasma, the FRAP assay, is presented as a novel method for assessing "antioxidant power." Ferric to ferrous ion reduction at low pH causes a colored ferrous-tripyridyltriazine complex to form. FRAP values are obtained by comparing the absorbance change at 593 nm in test reaction mixtures with those containing ferrous ions in known concentration. Absorbance changes are linear over a wide concentration range with antioxidant mixtures, including plasma, and with solutions containing one antioxidant in purified form. There is no apparent interaction between antioxidants. Measured stoichiometric factors of Trolox, alpha-tocopherol, ascorbic acid, and uric acid are all 2.0; that of bilirubin is 4.0. Activity of albumin is very low. Within- and between-run CVs are <1.0 and <3.0%, respectively, at 100-1000 micromol/liter. FRAP values of fresh plasma of healthy Chinese adults: 612-1634 micromol/liter (mean, 1017; SD, 206; n = 141). The FRAP assay is inexpensive, reagents are simple to prepare, results are highly reproducible, and the procedure is straightforward and speedy. The FRAP assay offers a putative index of antioxidant, or reducing, potential of biological fluids within the technological reach of every laboratory and researcher interested in oxidative stress and its effects.
Use of a free radical method to evaluate antioxidant activity
DOI:10.1016/S0023-6438(95)80008-5 URL [本文引用: 1]
Studies on the biological properties of medicinal fungus Inonotus hispidus
Identification of Inonotus hispidus and antioxidant and antimicrobial activities of different solvent extracts from its fruiting bodies
Illustations of pathogenetic wood-decaying fungi in China
Pathogenic wood-decaying fungi on woody plants in China
Wild edible and medicinal fungi in northeast China
The forest pathogens of root and butt rot on northeast China
Distribution of styrylpyrones in the basidiocarps of various Hymenochaetaceae
DOI:10.1016/0305-1978(82)90002-3 URL [本文引用: 1]
Pigments of fungi (Macromycetes)
This review summarises progress reported in the chemical, biological and mycological literature dealing with the isolation, characterisation and chemistry of pigments manufactured by those fungi that produce conspicuous fruit bodies (Macromycetes). Work that has appeared in the primary literature between September 1998 and May 2003 is covered, and 99 references are cited.
Effects of Inonotus hispidus extracts and compounds on human immunocompetent cells
DOI:10.1055/s-0042-111693 URL [本文引用: 1]
Characterization of the physicochemical properties and extraction optimization of natural melanin from Inonotus hispidus mushroom
DOI:10.1016/j.foodchem.2018.11.002 URL [本文引用: 1]
Effect of extraction techniques on the extraction and hypolipidemic activity in vitro of triterpenoids from Inonotus hispidus
Studies on the domestication and cultivation, anti-hypoglycemic and antioxidative effect of Inonotus hispidus
Research advances on chemical constituents and pharmacological effects of traditional Chinese medicine sanghuang—Inonotus hispidus
Mycelial culture of wild Inonotus hispidus parasitizing the jujube tree and the cultivation conditions of its fruit body on rice medium
A novel method for measuring antioxidant capacity and its application to monitoring the antioxidant status in premature neonates
DOI:10.1042/cs0840407
PMID:8482045
[本文引用: 1]

1. A new method has been developed for measuring the total antioxidant capacity of body fluids and drug solutions, based on the absorbance of the ABTS.+ radical cation. 2. An automated method for use on a centrifugal analyser, as well as a manual method, is described. 3. The procedure has been applied to physiological antioxidant compounds and radical-scavenging drugs, and an antioxidant ranking was established based on their reactivity relative to a 1.0 mmol/l Trolox standard. 4. The Trolox equivalent antioxidant capacity of plasma from an adult reference population has been measured, and the method optimized and validated. 5. The method has been applied to investigate the total plasma antioxidant capacity of neonates and how this may be compromised in prematurity.
Biological characteristics and cultivation of Inonotus hispidus parasitizing on Ulmus macrocarpa var. mongolica
Global diversity and systematics of Hymenochaetaceae with poroid hymenophore
DOI:10.1007/s13225-021-00496-4 [本文引用: 1]
Resource diversity of Chinese macrofungi: edible, medicinal and poisonous species
DOI:10.1007/s13225-019-00432-7 [本文引用: 1]
Biological characteristic of Inonotus hispidus
Chemical components and anti-tumour compounds from Inonotus hispidus
Studies on the chemical constituents and pharmacological activities of Inonotus hispidus and Fomitiporia ellipsoidia
Research progress of Inonotus hispidus
Study on the antioxidant and antibacterial activities of the extracts from Inonotus hispidus
Optimization on determination of polyphenols from Inonotus obliquus by Folin-Ciocalteu colorimetry
Antioxidant activities of medicinal fungus Sanghuangporus sanghuang during liquid cultivation
Accumulation of antioxidant phenolic constituents in submerged cultures of Inonotus obliquus
DOI:10.1016/j.biortech.2008.05.002 URL [本文引用: 1]
Enhanced production of total flavones and exopolysaccharides via Vitreoscilla hemoglobin biosynthesis in Phellinus igniarius
DOI:10.1016/j.biortech.2010.08.085
PMID:20855202
[本文引用: 1]

The Vitreoscilla hemoglobin gene (vgb) was expressed by chromosomal integration in Phellinus igniarius to alleviate oxygen limitation and improve metabolites yields during submerged fermentation. Firstly, an expression vector containing vgb was constructed, and transformed into protoplast from P. igniarius. Carbon monoxide difference spectrum absorbance assay showed that vgb was successfully expressed and had biological activity. In shake flasks, the vgb expression enhanced dry mycelial weight 1.32-fold and increased total flavones and exopolysaccharides production 1.78- and 1.33-fold, respectively. When P. igniarius (vgb+) and P. igniarius (vgb-) strains were cultured in bioreactor, Vitreoscilla hemoglobin in P. igniarius promoted the mycelia growth from 5.40 to 10.90 g/L and stimulated total flavones and exopolysaccharides synthesis; their maximum productions reached to 11.43 and 1.33 g/L. Furthermore, compared to P. igniarius (vgb-), the acetic acid accumulation in P. igniarius (vgb+) cultures decreased from 1.54 and 1.78 to 1.19 and 1.27 g/L in flask and bioreactor, respectively.Copyright © 2010 Elsevier Ltd. All rights reserved.
粗毛纤孔菌(Inonotus hispidus)的鉴定及其子实体不同溶剂提取物的抗氧化活性与抑菌活性研究
提取技术对粗毛纤孔菌三萜类化合物制备及体外降血脂作用的影响
DOI:10.7506/spkx1002-6630-201810044
[本文引用: 1]

为研究不同提取技术对粗毛纤孔菌三萜类化合物(triterpenoids from Inonotus hispidus,IHT)制备及体外降血脂作用的影响,选用粗毛纤孔菌菌丝体为原料,研究了高剪切技术、超声波技术、双水相技术、半仿生技术及溶剂回流技术对IHT提取率和对胆酸盐结合能力的影响,并采用红外光谱技术对IHT的结构进行初步分析。实验结果表明:5?种提取技术对IHT提取效果及降血脂功能影响均存在显著性差异(P<0.05),其中高剪切技术的IHT提取率最高,为(3.33±0.02)%,是溶剂回流技术((1.26±0.05)%)的2.64?倍。高剪切技术提取的IHT对胆酸盐的结合能力最显著(P<0.05),其降血脂活性与质量浓度呈剂量效应关系,且质量浓度在40?mg/mL时,与甘氨胆酸钠的结合能力为(1.01±0.03)μmol/100?mg,与胆酸钠的结合能力为(0.47±0.04)μmol/100?mg,与牛磺胆酸钠的结合能力为(1.31±0.09)μmol/100?mg,相对辛伐他汀的吸附率分别为36.53%、27.92%、46.33%。红外光谱分析显示,高剪切技术提取的IHT符合三萜类物质的特征结构,且特征吸收峰最强。本研究结果为IHT提取技术的选择及降血脂药物的开发利用提供理论依据。?
寄生枣树的野生粗毛纤孔菌菌丝培养及其子实体大米栽培条件